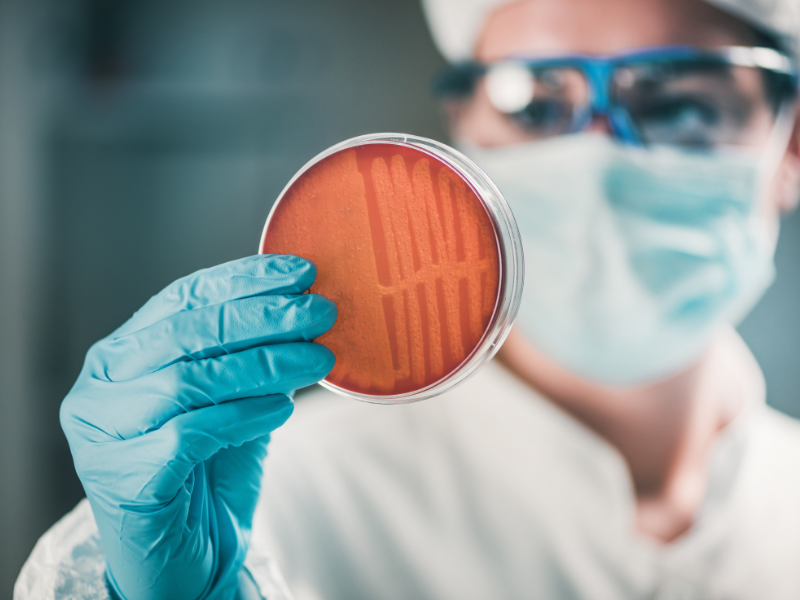

Što radi mikrobiolog?
Što radi mikrobiolog?
Zanima te kako na koji način čovjek i priroda žive? Na satima biologije i kemije, ti je bilo najzanimljivije kada ste radili pokuse? Na pomisao da mikroorganizmi neprestano puze na nama ljudima, ti si znatiželjan, a ne zgrožen? Onda bi posao mikrobiologa možda bio dobar izbor za tebe. Kao mikrobiolog, laboratorij je tvoje kraljevstvo. Tamo se brineš o bakterijskim sojevima i kulturama, planiraš eksperimente, izvršavaš ih i zapisuješ u skladu s tim. Na primjer, razvijaš lijekove ili poboljšavaš postojeće, istražuješ funkcioniranje određenog mikroorganizma i vršiš promjene genetskog inženjeringa. Tijekom cijelog rada, morati ćeš slijediti sve sigurnosne i ekološke smjernice u laboratoriju.
Koje su vještine potrebne za mikrobiologa?
Prije svega, moraš sa sobom donijeti relevantnu stručnost. Trebao bi biti upoznat s mikrobiologijom, molekularnom biologijom, genetikom i biokemijom te, ovisno o tvojoj specijalizaciji, posjedovati znanje u tom području. Kao mikrobiolog moraš biti precizan u svom radu, te svoje eksperimente ponekada moraš vremenski planirati i uvijek paziti da sve bude potpuno sterilno, inače ćeš morati sve raditi ispočetka. Obzirom da radiš s manjim količinama kemikalija, moraš ih znati točno izmjeriti. Posebno u području biologije, tehnologija postaje sve važnija, te nije dovoljno samo poznavati opremu u laboratoriju, već i softvere koje koristiš u radu. Sva je znanstvena literatura pisana na engleskom jeziku, tako da je za ovo zanimanje potrebno znanje engleskog jezika. U znanosti radiš s raznim kolegama: asistentima, pripravnicima, istraživačima, profesorima. Stoga moraš biti u mogućnosti raditi u timu, te se nositi s različitim karakterima. Na kraju, potrebna ti je moć multitaskinga, jer ćeš često u isto vrijeme raditi na više različitih pokusa.
Hard skills
- Znanje u mikro- i molekularnoj biologiji
- Relevantne računalne vještine
- Engleski jezik u govoru i pismu
Soft skills
- Točnost
- Sposobnost multitaskinga
- Timski rad
Kako postati mikrobiolog?
Da biste postali mikrobiolog, obično je potrebno završiti fakultet u mikrobiologiji ili srodnom području, te se specijalizirati za proučavanje mikroorganizama i mikrobioloških procesa.
Kakva je budućnost mikrobiologa?
Kao mikrobiolog, imaš razne mogućnosti zaposlenja. Možeš raditi u farmaceutskim tvrtkama, ali i u medicini, na primjer u bolnici ili dijagnostičkom laboratoriju. Čak i temeljna istraživanja na sveučilištima i istraživačkim institutima zahtijevaju tvoje znanje i vještine. Privatni sektor se malo razlikuje, ali i tu imaš dobre mogućnosti za napredovanjem. Korak po korak, možeš preuzeti više odgovornosti u području organizacije laboratorija, optimizacije procesa i upravljanja osobljem. Ali to također znači manje vremena u laboratoriju, a više vremena u uredu.